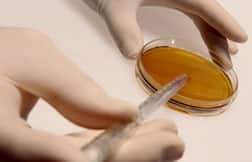

- Science & Research
- Science News
- Newsletter
- 2012
- April 6
Newsletter
Newsletter
Mayo Clinic Study Finds GLA Inhibits Pancreatic Cancer Cell Growth
Mayo Clinic study finds GLA inhibits pancreatic cancer cell growth
Friday, April 6, 2012. The results of a study reported by Mayo Clinic pathologist Ruth Lupu, PhD at the American Association for Cancer Research Annual Meeting 2012, held in Chicago from March 31 to April 4, revealed a protective effect for gamma-linolenic acid (GLA), an omega-6 fatty acid that is available as a dietary supplement, against the growth of one type of pancreatic cancer. "One of the most devastating facts about pancreatic cancer is the paucity of effective drugs that exist to halt a tumor," Dr Lupu commented. "We knew from studies done about 20 years ago that polyunsaturated fatty acids such as GLA could influence cancers in general, but we didn't know which type of fatty acids and to what degree." Dr Lupu's team initially evaluated the effects of GLA in a number of cultured pancreatic cancer cell lines and discovered an inhibitory effect in a subtype that expresses a gene for fatty acid synthase. In earlier research, the team showed that fatty acid synthase is highly expressed in pancreatic adenocarcinomas and may be a marker of poor survival. "This was very exciting finding, because we realized that GLA was working selectively and had a particular target within cells," Dr Lupu remarked. When GLA was tested in cells with high fatty acid synthase levels, 85 percent of cancer cell growth was inhibited, which is a significant improvement over gemcitabine, the standard chemotherapy for pancreatic cancer which provides only a modest benefit. When the two compounds were combined, the researchers observed complete inhibition of pancreatic cancer cell growth. The combination was also demonstrated to significantly inhibit pancreatic cancer growth in mice. "The two treatments worked synergistically, and we achieved a significantly higher inhibition of cell growth and higher incidence of dead pancreatic carcinoma cells," Dr Lupu stated. "We don't yet know why the combination works better, but we know that many drugs work better when used together." Dr Lupu plans to test the combination of GLA in gemcitabine in humans with cancer of the pancreas. "Since resistance to gemcitabine and other chemotherapy drugs can be an issue in treatment, we hope GLA will work in combination with other chemotherapy drugs to offer patients a wide range of treatment opportunities," she said. | ||||||||||||||||||||||||||||||||||||||||
![]() | ||||||||||||||||||||||||||||||||||||||||
| ||||||||||||||||||||||||||||||||||||||||
| ||||||||||||||||||||||||||||||||||||||||
![]() | ||||||||||||||||||||||||||||||||||||||||
| ||||||||||||||||||||||||||||||||||||||||
| ||||||||||||||||||||||||||||||||||||||||
The latest news on aging, nutrition, and vitamins
- Probiotics and Antidepressants: Do They Work Together Through the Gut-Brain Axis?
- Fruits and Vegetables May Improve Sleep Quality, According to New Research
- Avocado Nutrition Facts: 10 Benefits for a Stronger, Healthier Body
- Can Gut Disorders and Vitamin Deficiencies Predict Alzheimer’s and Parkinson’s?
Lab
Testing
How Life Extension lab testing works